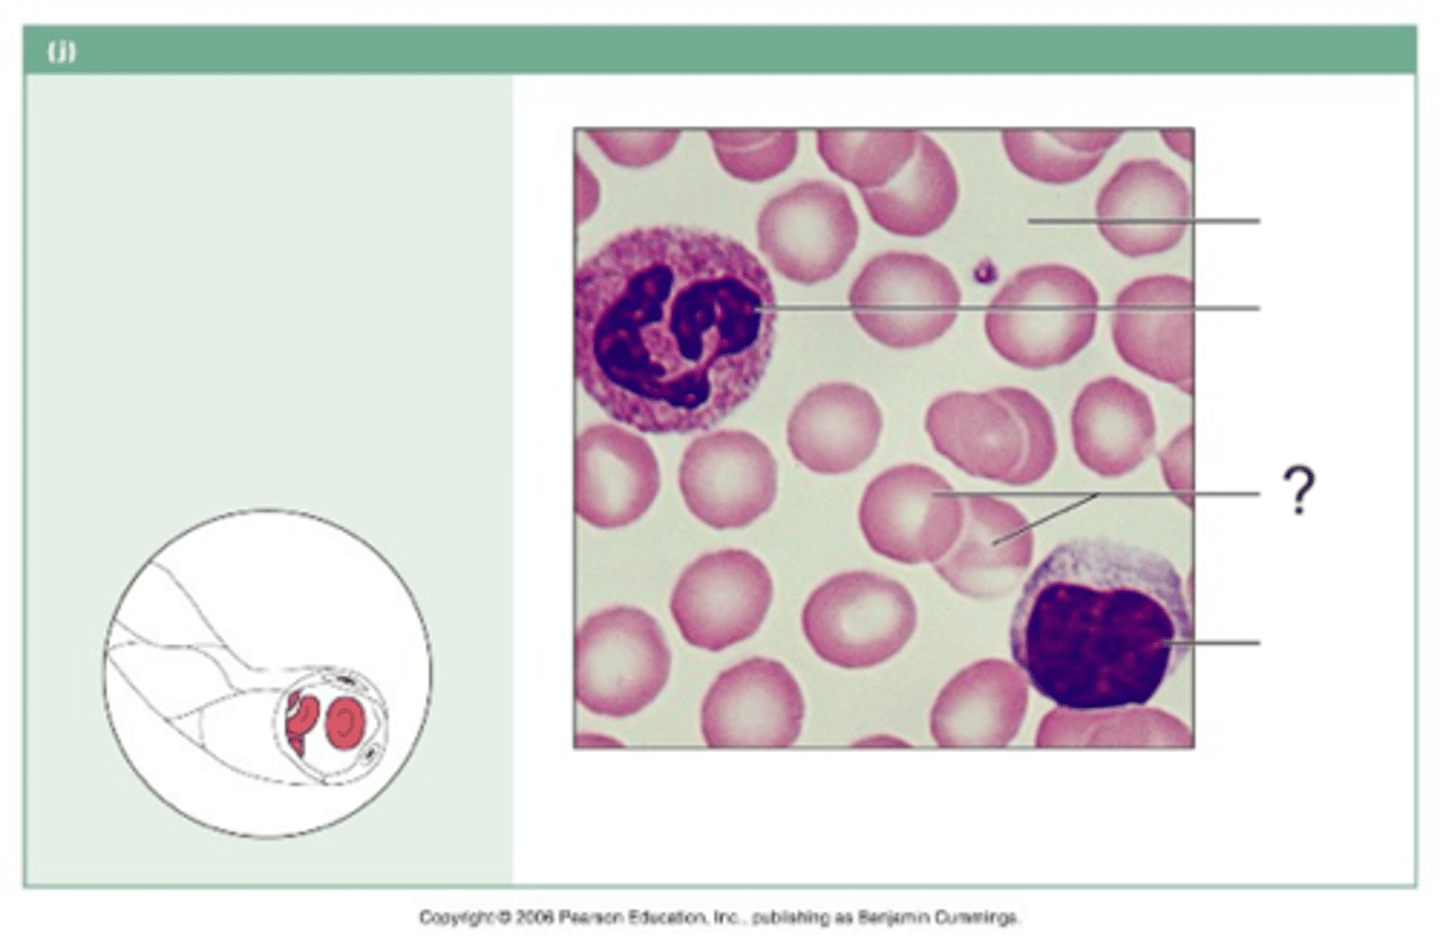
<p>?</p>
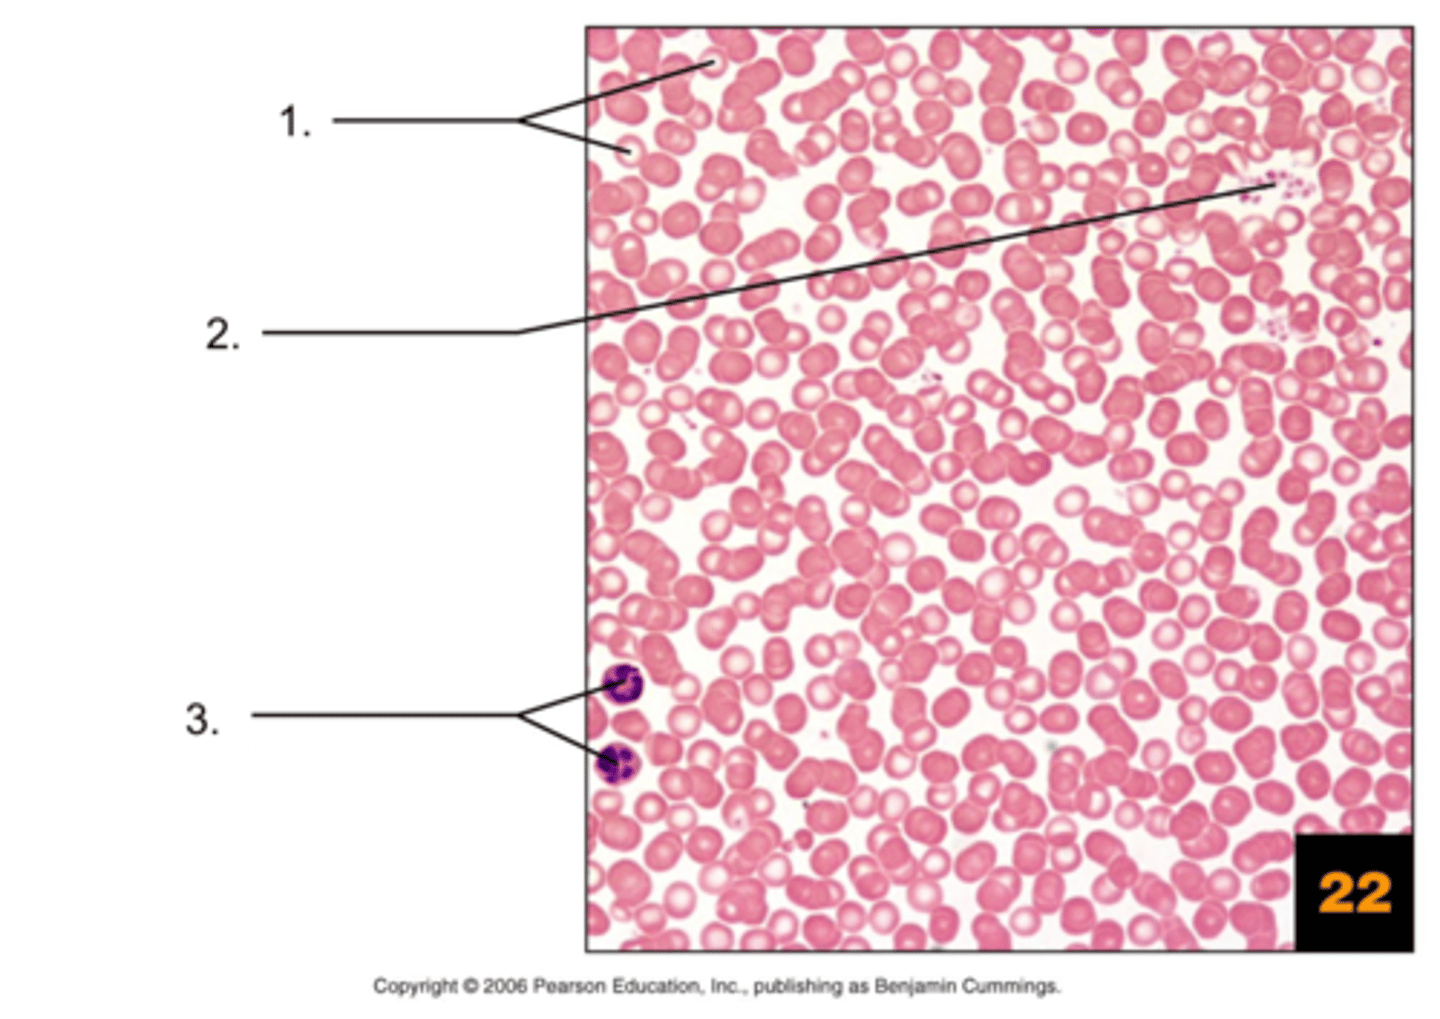
<p>3.</p>
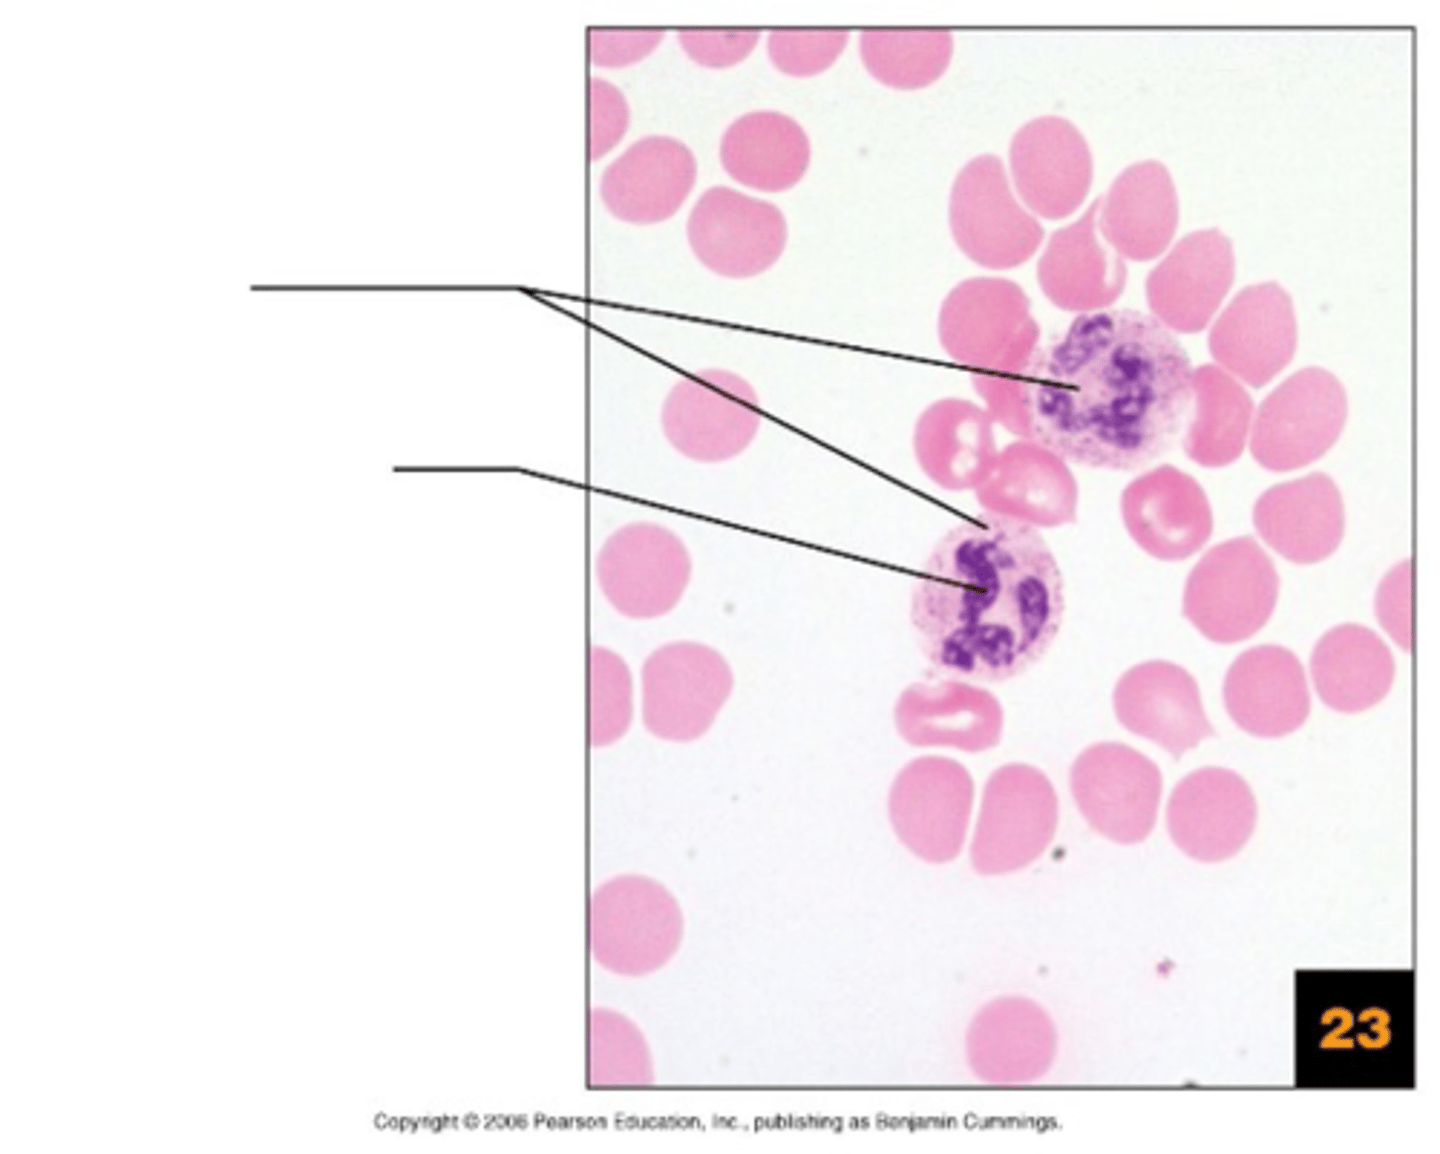
knowt flashcard image
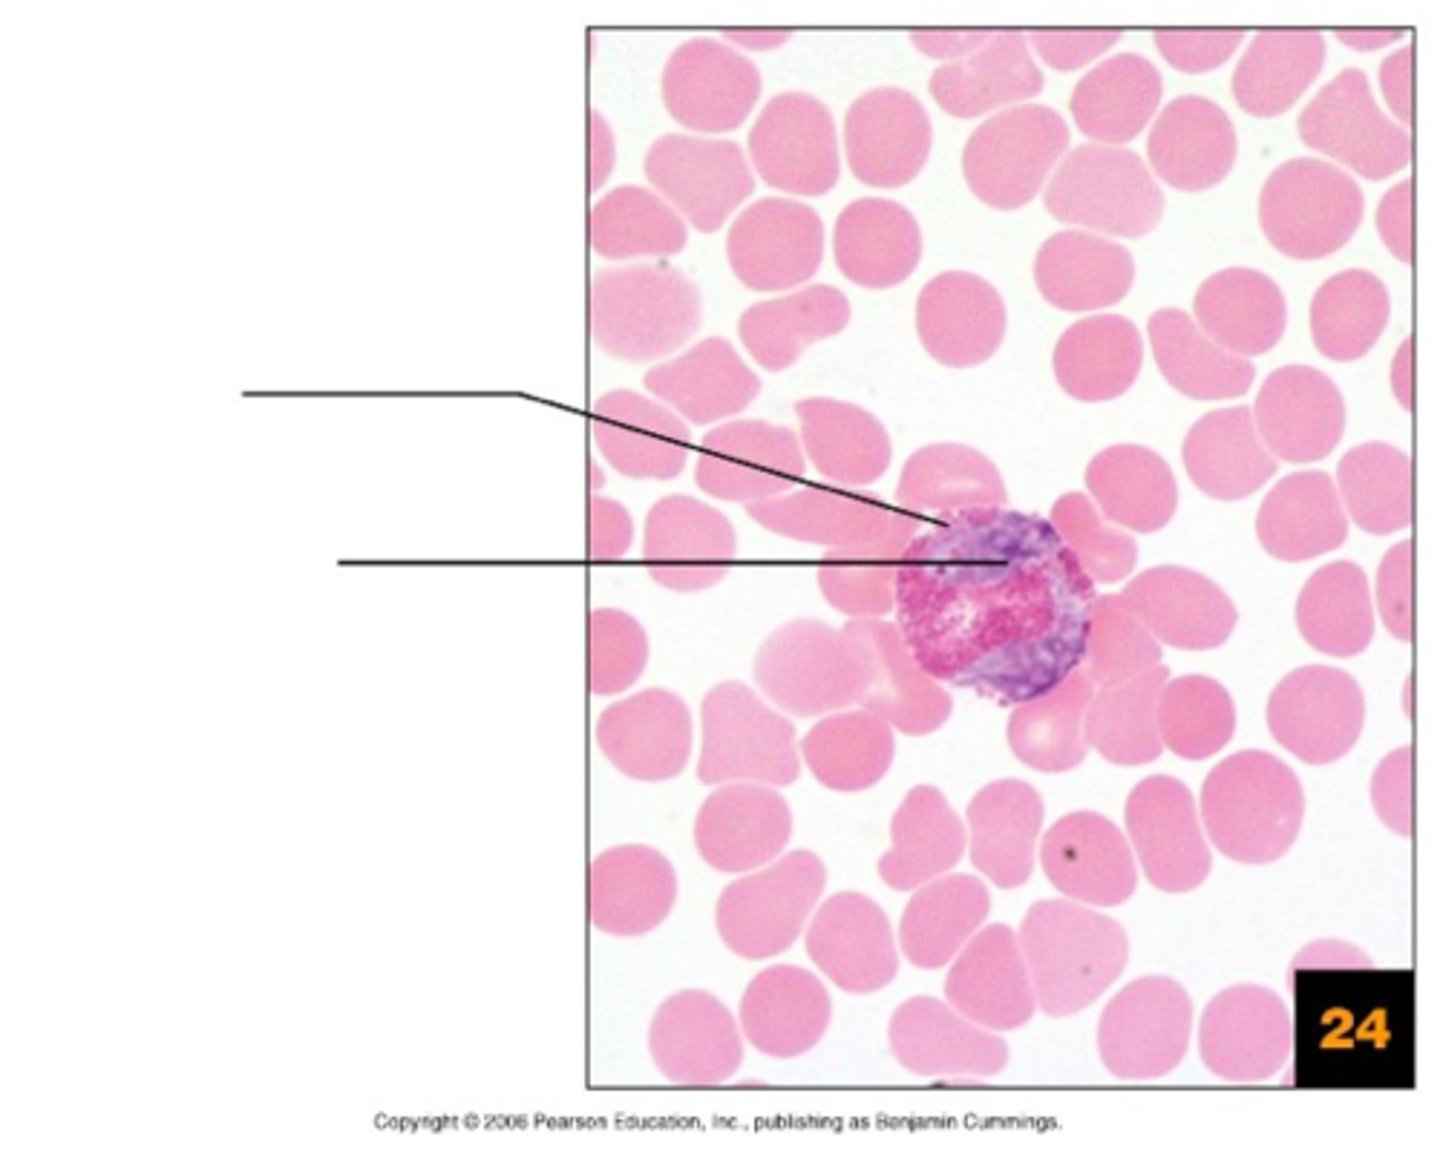
knowt flashcard image
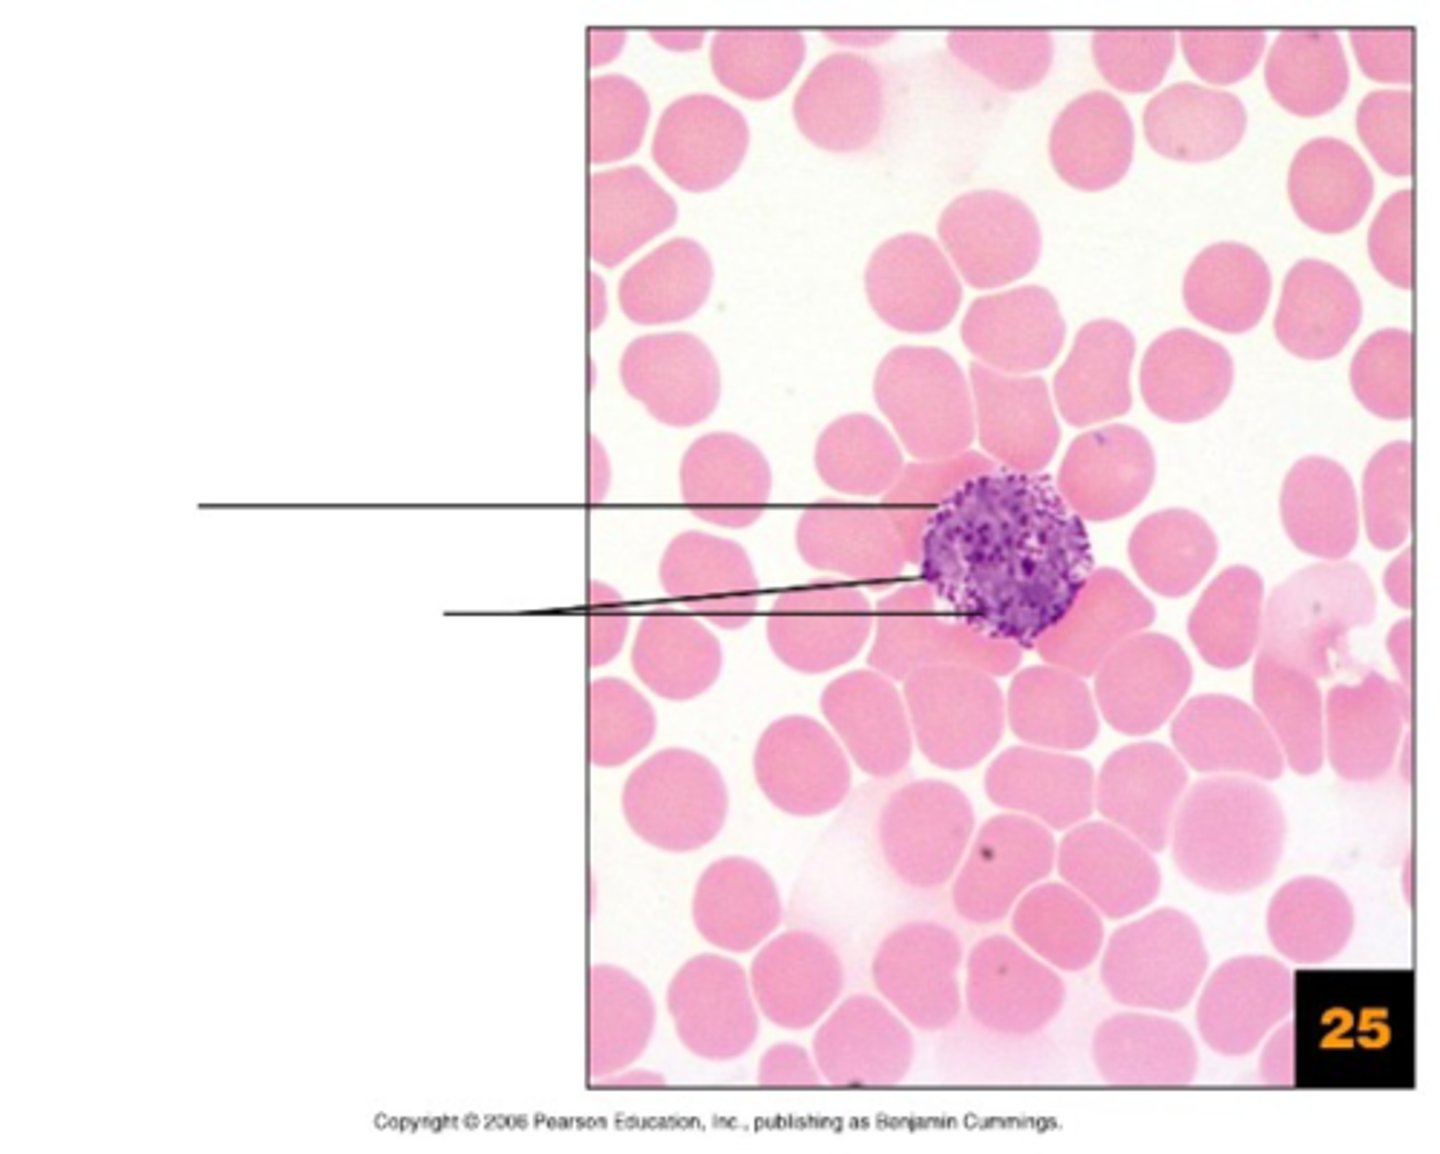
knowt flashcard image
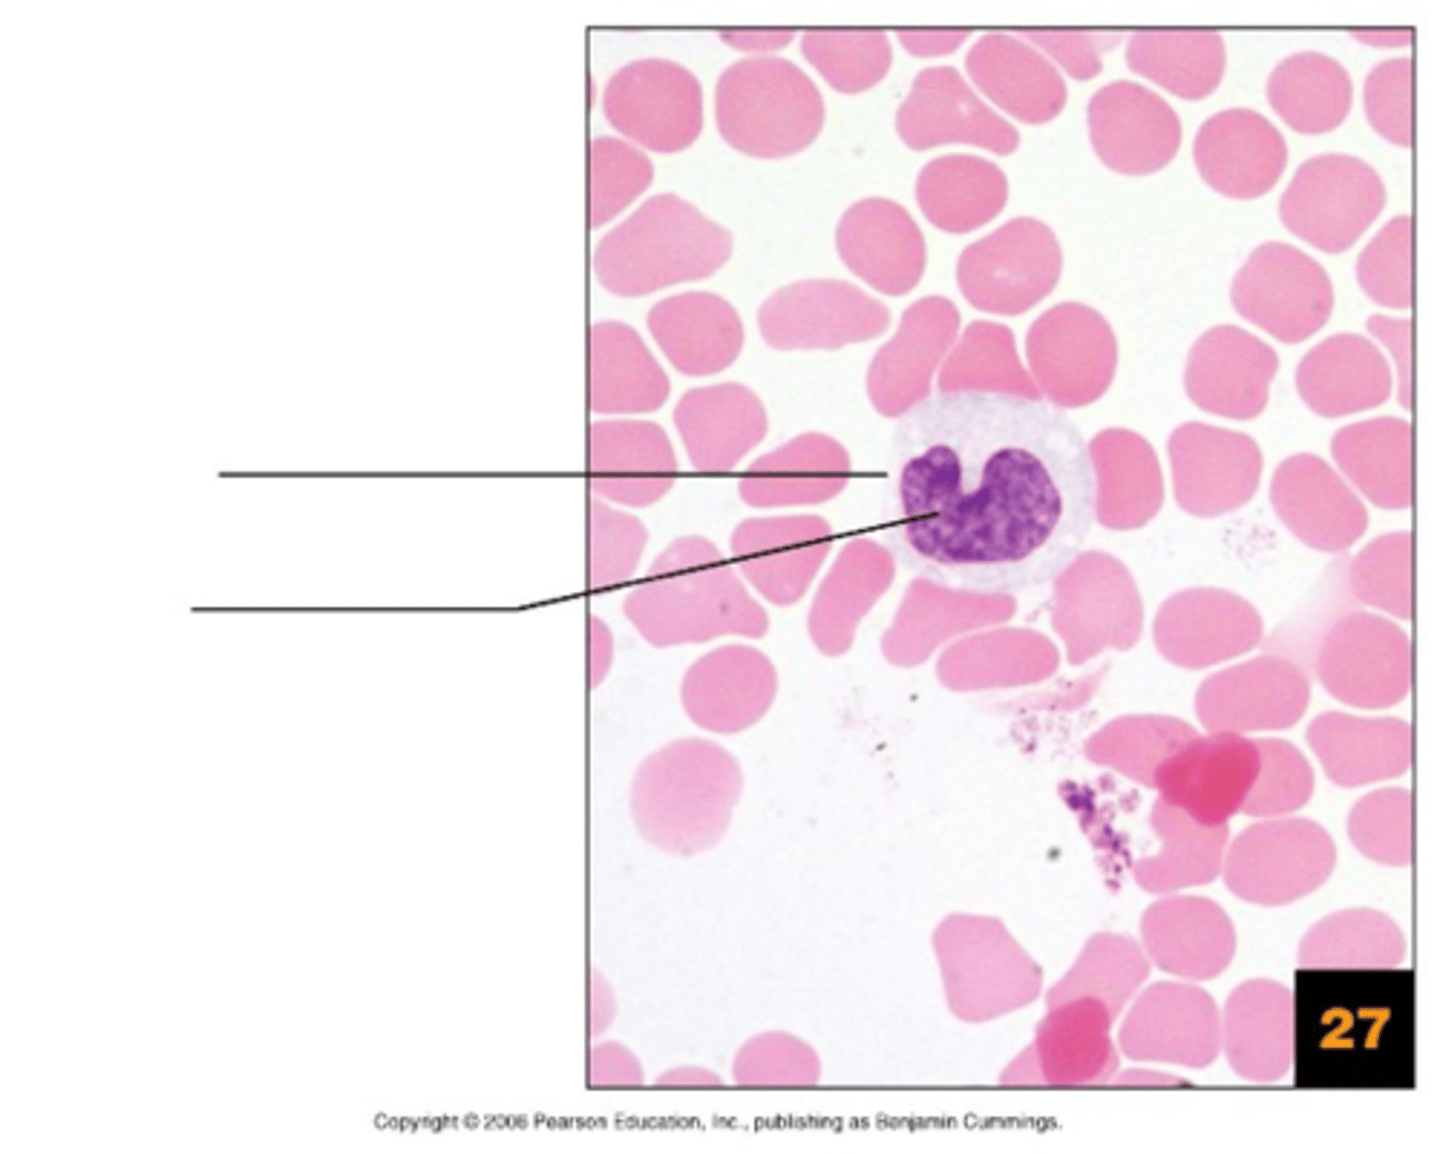
knowt flashcard image
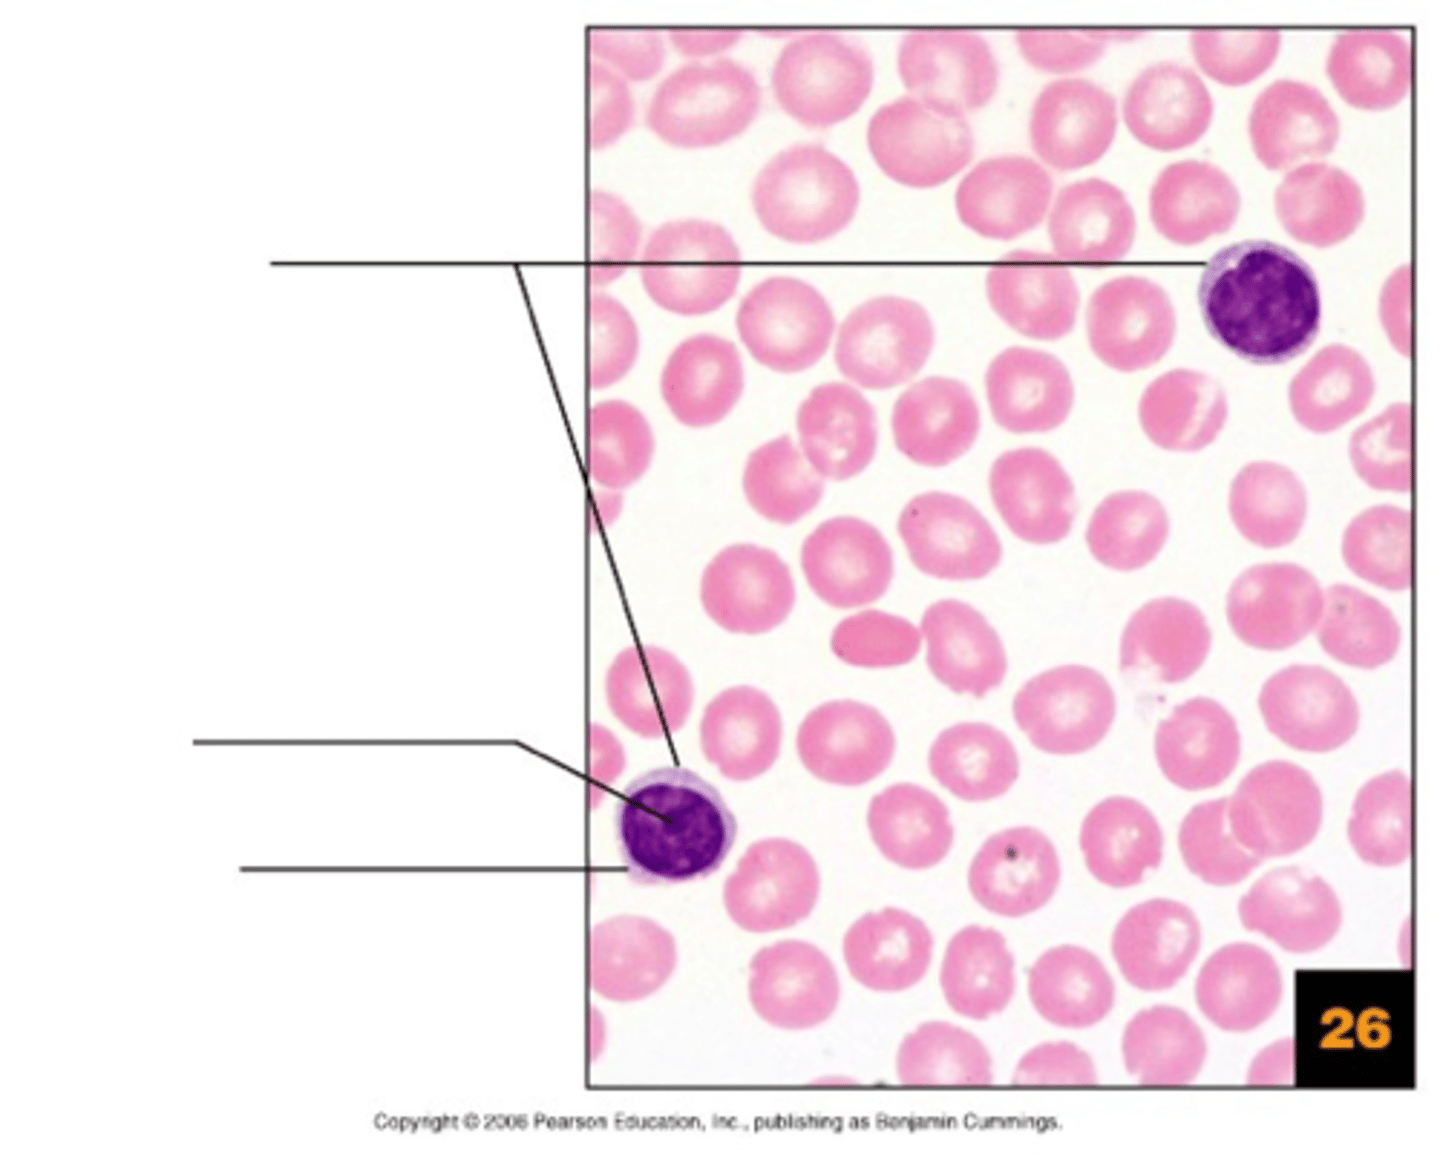
knowt flashcard image
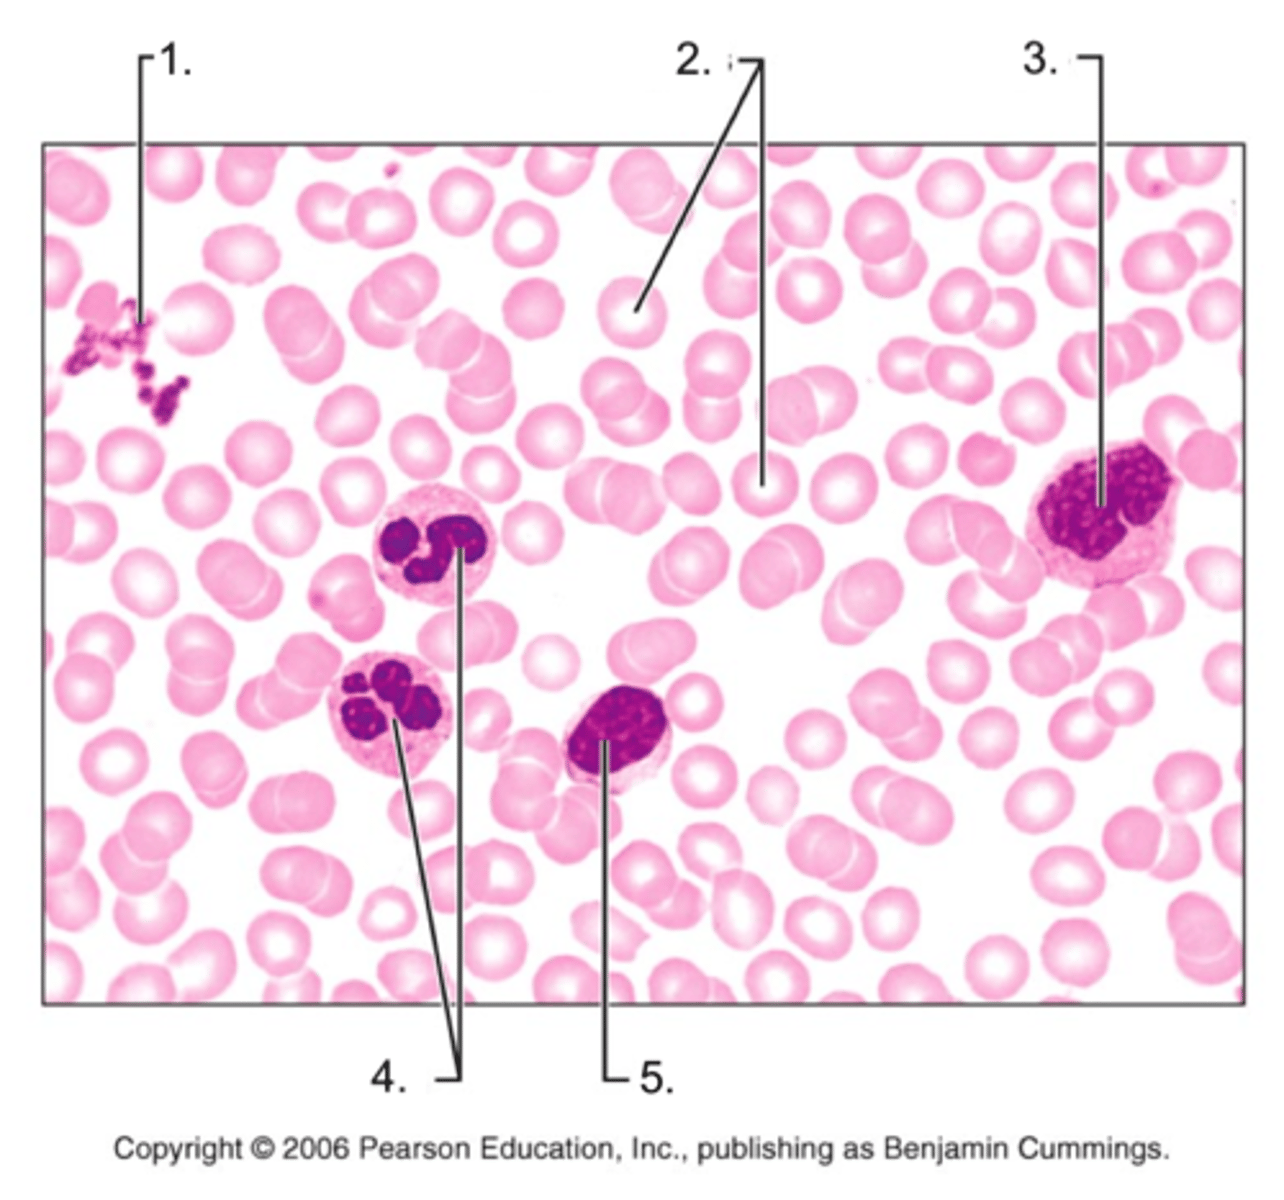
<p>5.</p>

1/142
Looks like no tags are added yet.
Name | Mastery | Learn | Test | Matching | Spaced | Call with Kai |
|---|
No analytics yet
Send a link to your students to track their progress
external ear
1.

auricle
2.

helix
3.

lobule
4.

external acoustic meatus
5.

tympanic membrane
6.

pharyngotympanic tube
7.

middle ear
8.

internal ear
9.

ora serrata
1.

ciliary muscle
2.

ciliary zonule
3.

cornea
4.

iris
5.

pupil
6.

anterior pole
7.

anterior segment (aqueous humor)
8.

lens
9.

scleral venus sinus
10.

posterior segment (vitreous humor)
11.

sclera
12.

choroid
13.

retina
14.

macula lutea
15.

fovea centralis
16.

posterior pole
17.

optic nerve
18.

central artery and vein of the retina
19.

optic disc (blind spot)
20.

pineal gland
1.

hypothalamus
2.

pituitary gland
3.

thyroid gland
4.

parathyroid glands
5.

thymus
6.

adrenal glands
7.

pancreas
8.

ovary
9.

testis
10.

red blood cell
?
Erythrocytes
1.

platelets
2.

leukocytes (neutrophils)
3.
neutrophil
eosinophil
basophil
monocyte
lymphocyte
platelets
1.

Erythrocytes
2.

monocyte
3.

neutrophils
4.

Lymphocyte
5.
anti-a
1.

anti-b
2.

type AB (contains agglutinogens A and B; agglutinates with both sera)
3.

type B (contains agglutinogen B)
4.

type A (contains agglutinogen A)
5.

type O (contains no agglutinogens)
6.

aortic arch (fat covered)
1.

pulmonary trunk
2.

right atrium
3

left auricle of left atrium
4.

anterior interventricular artery
5.

right ventricle
6.

apex of heart (left ventricle)
7.

pectinate muscles
1

interatrial septum
2

opening of inferior vena cava
4

opening of coronary sinus
4

cusp of tricuspid valve
5

right ventricle (not cut open)
6

interventricular sulcus
8

crista terminalis
9

crista terminalis
9

opening of superior vena cava
10

myocardium of left ventricle (cut open)
12

left subclavian vein
1

descending aorta
2

ligamentum arteriosum
3

left pulmonary artery
4

left pulmonary veins
5

left atrium
6

coronary sinus
7

left ventricle
8

brachiocephalic trunk
9

left common carotid artery
10

superior vena cava
11

right pulmonary arteries
12

right pulmonary veins
13

right atrium
14

inferior vena cava
15

right ventricle
16

posterior inter ventricular sulcus
17

pulmonary valve
1

aortic valve
2

area of cutaway
3

mitral valve
4

tricuspid valve
5

fibrous skeleton
6
